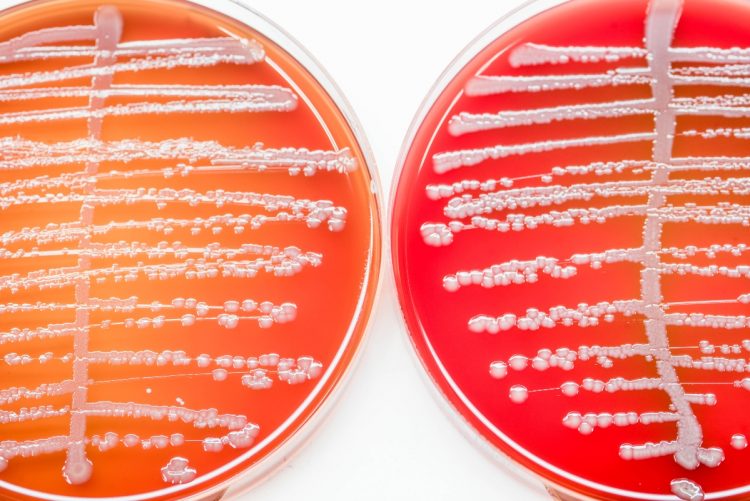
Urinocoltura che cos’è, a cosa serve, quando si esegue, risultati

L'urinocoltura o urocoltura è un esame che valuta la presenza o meno di microrganismi nell'urina.
Procedura
Nell'urinocoltura si effettua un prelievo dell'urina, con procedura sterile; solitamente sono necessari 5 ml inseriti in una provetta.
Prelievo tramite "Mitto intermedio"
Si preleva il "mitto intermedio" ovvero non la prima minzione (getto di urina), poiché nella prima vi può essere contaminazione da batteri commensali dell'uretra.
Prelievo di un campione da catetere vescicale
In pazienti portatori di catetere vescicale, si procede raccogliendo il campione aspirando asetticamente dal diaframma perforabile del catetere urinario previa chiusura tramite un morsetto o una pinza autostatica pulita del tubo posto al di sopra della membrana.
Conservazione
I campioni di urina devono essere immediatamente messi in coltura altrimenti si corre il rischio che i microrganisimi vi si moltiplichino, se questo non dovesse essere possibile i campioni devono essere refrigerati o messi in un liquido batteriostatico che impedisca la moltiplicazione dei germi. La presenza di germi dà luogo alla crescita di colonie batteriche dopo alcuni giorni. Si considera positivo un numero di oltre 10.000 batteri/ml.
Esame
In seguito si effettuano diluizioni (fino a 1 parte su un miliardo) e si procede con la metodologia del "doppio" come precauzione da eventuali incidenti: poi su piastra si va a saggiare la presenza di Escherichia coli o di altri Enterobatteri, grazie all'utilizzo di un'ansa di platino appositamente sterilizzata con becco di Bunsen.
Per l'Escherichia coli si utilizza un terreno di Mac Conkey (terreno selettivo per Gram negativi), mentre per altri enterobatteri si utilizza il TSA (Trypticase Soy Agar).
Test aggiuntivo
In base allo sviluppo di batteri in una o entrambe le due piastre, si va a saggiare la resistenza agli antibiotici, mediante l'antibiogramma.
Note
Altri progetti
- Wikizionario contiene il lemma di dizionario «urinocoltura»
![]()

![]()
